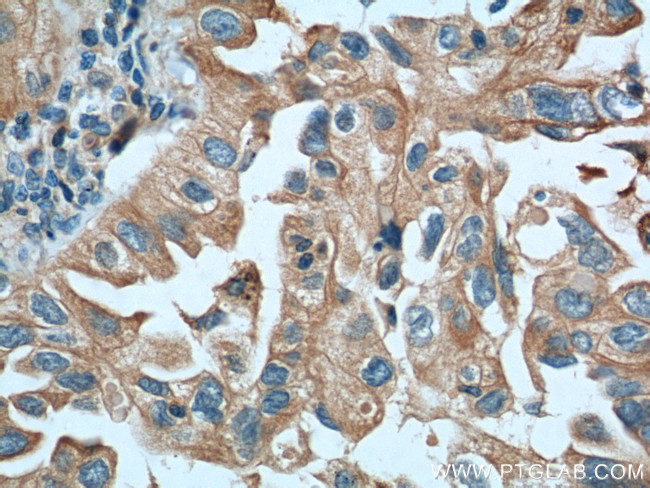
IGSF2 Antibody in Immunohistochemistry (Paraffin) (IHC (P))

Search
Proteintech
IGSF2 Monoclonal Antibody (1E6A7)
{{$productOrderCtrl.translations['antibody.pdp.commerceCard.promotion.promotions']}}
{{$productOrderCtrl.translations['antibody.pdp.commerceCard.promotion.viewpromo']}}
{{$productOrderCtrl.translations['antibody.pdp.commerceCard.promotion.promocode']}}: {{promo.promoCode}} {{promo.promoTitle}} {{promo.promoDescription}}. {{$productOrderCtrl.translations['antibody.pdp.commerceCard.promotion.learnmore']}}
产品信息
66333-1-IG
种属反应
宿主/亚型
分类
类型
克隆号
抗原
偶联物
形式
浓度
规格
纯化类型
保存液
内含物
保存条件
运输条件
产品详细信息
Immunogen sequence: ETWMFITKK QTDQTTLRIQ PAVKDFQVNI TADSLFAEGK PLELVCLVVS SGRDPQLQGI WFFNGTEIAH IDAGGVLGLK NDYKERASQG ELQVSKLGPK AFSLKIFSLG PEDEGAYRCV VAEVMKTRTG SWQVLQRKQS PDSHVHLRKP AARSVVVSTK NKQQVVWEGE TLAFLCKAGG AESPLSVSWW HIPRDQTQPE FVAGMGQDGI VQLGASYGVP SYHGNTRLEK MDWATFQLEI TFTAITDSGT YECRVSEKSR NQARDLSWTQ KISVTVKSLE SSLQVSLMSR QPQVMLTNTF DLSCVVRAGY SDLKVPLTVT WQFQPASSHI FHQLIRITHN GTIEW (260-603 aa encoded by BC136484)
靶标信息
CD101, also known as the V7 antigen, is a transmembrane glycoprotein and a member of the immunoglobulin superfamily. It is characterized by 7 Ig-like IgV domains and a short cytoplasmic tail with several phosphorylation sites. CD101 forms a disulfide-linked homodimer, although its precise function remains unknown. Expression of CD101 is observed on monocytes, granulocytes, dendritic cells, Langerhans cells, and activated T cells. It is also found on a subset of CD25+Foxp3+ regulatory T cells, which exhibit higher suppressive properties in vitro and in vivo. CD101 plays a role in modulating immune responses. Cross-linking CD101 can antagonize TCR/CD3-mediated lymphocyte activation, while CD101+ CD28+ T cells are highly responsive to CD28 signaling. In combination with anti-CD28 or suboptimal levels of anti-CD3, anti-CD101 can enhance proliferation, suggesting an activating role. The monoclonal antibody BB27 has been shown to inhibit T cell reactivity in allogeneic and antigen-specific mixed DC-T cell cultures. In mice, CD101 is expressed on a subpopulation of regulatory T cells (CD4+, CD25+, Foxp3+) with high suppressor activity. In humans, CD101 expression on peripheral blood mononuclear cells (PBMCs) stains approximately 30% of Foxp3+ cells, although studies have not confirmed higher suppressor activity in the human CD101+ population.
仅用于科研。不用于诊断过程。未经明确授权不得转售。
篇参考文献 (0)
生物信息学
蛋白别名: CD101; Cell surface glycoprotein V7; EWI immunoglobulin subfamily member EWI-101; EWI-101; Glu-Trp-Ile EWI motif-containing protein 101; IgSF2; Immunoglobulin superfamily member 2; immunoglobulin superfamily, member 2; leukocyte surface protein; RP11-27K13.2; unnamed protein product
基因别名: CD101; EWI-101; EWI101; Gm1016; Gm734; IGSF2; V7
UniProt ID: (Human) Q93033, (Mouse) A8E0Y8
Entrez Gene ID: (Human) 9398, (Mouse) 630146